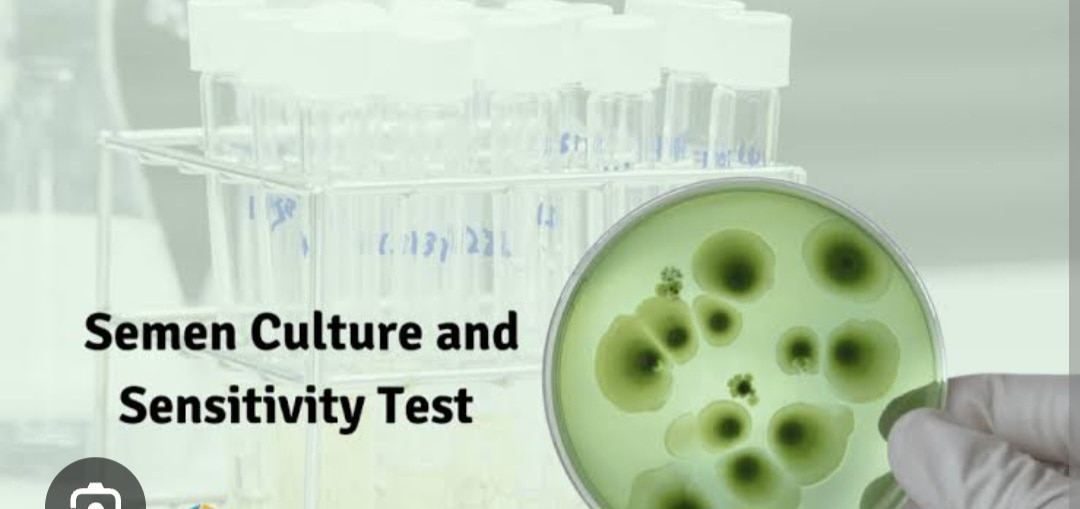

Description
Semen culture and sensitivity test - Femelife IVFA semen culture is a lab test used to detect infections in the male reproductive tract by checking a semen sample for bacteria, fungi, or other microorganisms. It is important for diagnosing conditions that can affect fertility, such as prostatitis or epididymitis, and is often recommended for men experiencing symptoms like painful urination, unusual semen discharge, or unexplained infertility. The test helps identify the specific microbe causing the infection, which guides the doctor in prescribing the correct treatment, often antibiotics. Purpose of a semen culture Identify infections: It diagnoses infections in the urogenital tract that can be caused by bacteria, fungi, or other microorganisms. Investigate infertility: Infections in the semen can affect sperm production and transport, so this test is often recommended for couples undergoing fertility treatment. Diagnose specific symptoms: It is helpful for individuals experiencing painful ejaculation, burning during urination, abnormal semen color or smell, or pain and swelling in the testicles. Guide treatment: By identifying the specific pathogen, the test helps doctors determine the most effective antibiotic or other treatment. Check STDs: The test can help identify sexually transmitted diseases caused by pathogens like Chlamydia trachomatis or Neisseria gonorrhoeae. Monitor treatment: It can also be used to check if a treatment for an infection has been successful. Who should get a semen culture Men with symptoms such as painful ejaculation, painful urination, or unusual semen discharge. Individuals with chronic prostatitis or recurrent urinary infections. Men with unexplained infertility. Couples undergoing fertility treatments like IVF or intrauterine insemination Welcome to Nidan Pathology Laboratory, your trusted partner in comprehensive healthcare services., we specialize in delivering accurate pathology blood tests and preventive health check packages. Our commitment lies in providing accessible healthcare solutions to the residents of Pimpri Chinchwad Pune city. With a focus on convenience and affordability, we offer free home collection services, ensuring that healthcare remains convenient and accessible to all. Experience quality healthcare services at affordable prices with Nidan Pathology Laboratory – your trusted healthcare partner in Pimpri Chinchwad Pune. We are fast growing health care organization. A pioneer in the health care arena, Nidan Pathology Laboratory has been at the fore front of world class health care services. Our fundamental mission is to propagate healthier living for all our citizen. Nidan Pathology Laboratory is doing a pivotal role in raising the bar of health diagnostic accuracy, technological equipment, customer experience and research-driven empathetic service in the health industry. The company runs health care services like-: pharmaceutical, herbal & nutraceutical company, other hand company also working with hospitals & clinic, diagnostics, ambulance services, blood bank, ngo, old age home care, pet care & medicine, nursing services, online medicine, online consultation, and also work with concept of health care @ the home services. In our country the healthcare industry is undergoing a revolutionary change due to the increasing awareness about lifestyle disease, growth in gdp, knowledge about preventive healthcare, growing health insurance market, and growing government expences on healthcare. Why Choose Nidan Pathology Laboratory? Regular checkups are an essential part of maintaining good health. At our pathology lab, we offer a comprehensive range of services to help you stay on top of your health game. Our team of experts is committed to providing you with the highest level of care and support, using the latest technology and techniques. Mission, Vision, Value MISSION A reliable, one-stop-solution for all healthcare needs of all categories of patients. To create impact by becoming an active participant in local community initiatives and contribute to its well-being and development. Vision At Nidan Pathology Laboratory we aim to dedicate ourselves to human care through excellence in health care services and improving health standards through preventive care. Value QUALITY EFFICIENCY COST INNOVATION DEPENDABILITY SPEED
576min